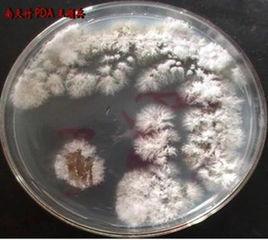
植物內生菌 植物內生菌

概述
釋義
植物內生菌的分離植物內生菌(Endophyte)是指那些在其生活史的一定階段或全部階段生活於健康植物的各種組織和器官內部的真菌或細菌。
由來
100多年前人們就已發現在健康植物組織的內部也有微生物存在,這類微生物在文獻中後來被稱為植物內生菌;克洛珀( Kloepper )第一次提出了“植物內生菌”的概念。早在1926年,Perotti等人在許多健康植物根組織內發現了細菌,被確定為植物體記憶體在細菌的起始點。植物內生細菌普遍存在於高等植物中,木本、草本植物,單子葉植物和雙子葉植物內均有內生細菌。
種類
植物內生菌高產水稻內生真菌(Endophytic fungi)
內生細菌(Endophytic bacteria)
內生放線菌(Endophytic actinomyces)等。
特性
植物內生菌、增產菌內生細菌在植物體內具有穩定的生存空間,不易受環境條件的影響,可以在植物體內獨立的分裂繁殖和傳遞,使之成為生物防治中有潛力的微生物農藥、增產菌或作為潛在的生防載體菌而加以利用。
相關資料
《植物內生菌》主要內容簡介:植物內生菌名稱是經歷了幾十年的發展才逐漸形成的。雖然內生菌早在100多年前就已經被發現。但由於被感染的寄主植物不表現出症狀,因此長期以來,內生菌的存在一直被忽略。直到20世紀30年代,發現給畜牧業帶來嚴重損失的牲畜中毒事件是由於牲畜食用了感染內生真菌的牧草所致,植物內生菌作為一T種新的微生物資源才受到了廣泛的關注。
《植物內生菌》出版社: 中國農業科學技術出版社; 第1版 (2010年5月1日)
平裝: 174頁
正文語種: 簡體中文
開本: 32
ISBN: 9787511602008, 7511602002
條形碼: 9787511602008
商品尺寸: 20 x 13.8 x 1 cm
商品重量: 259 g
ASIN: B003YHKX4Y